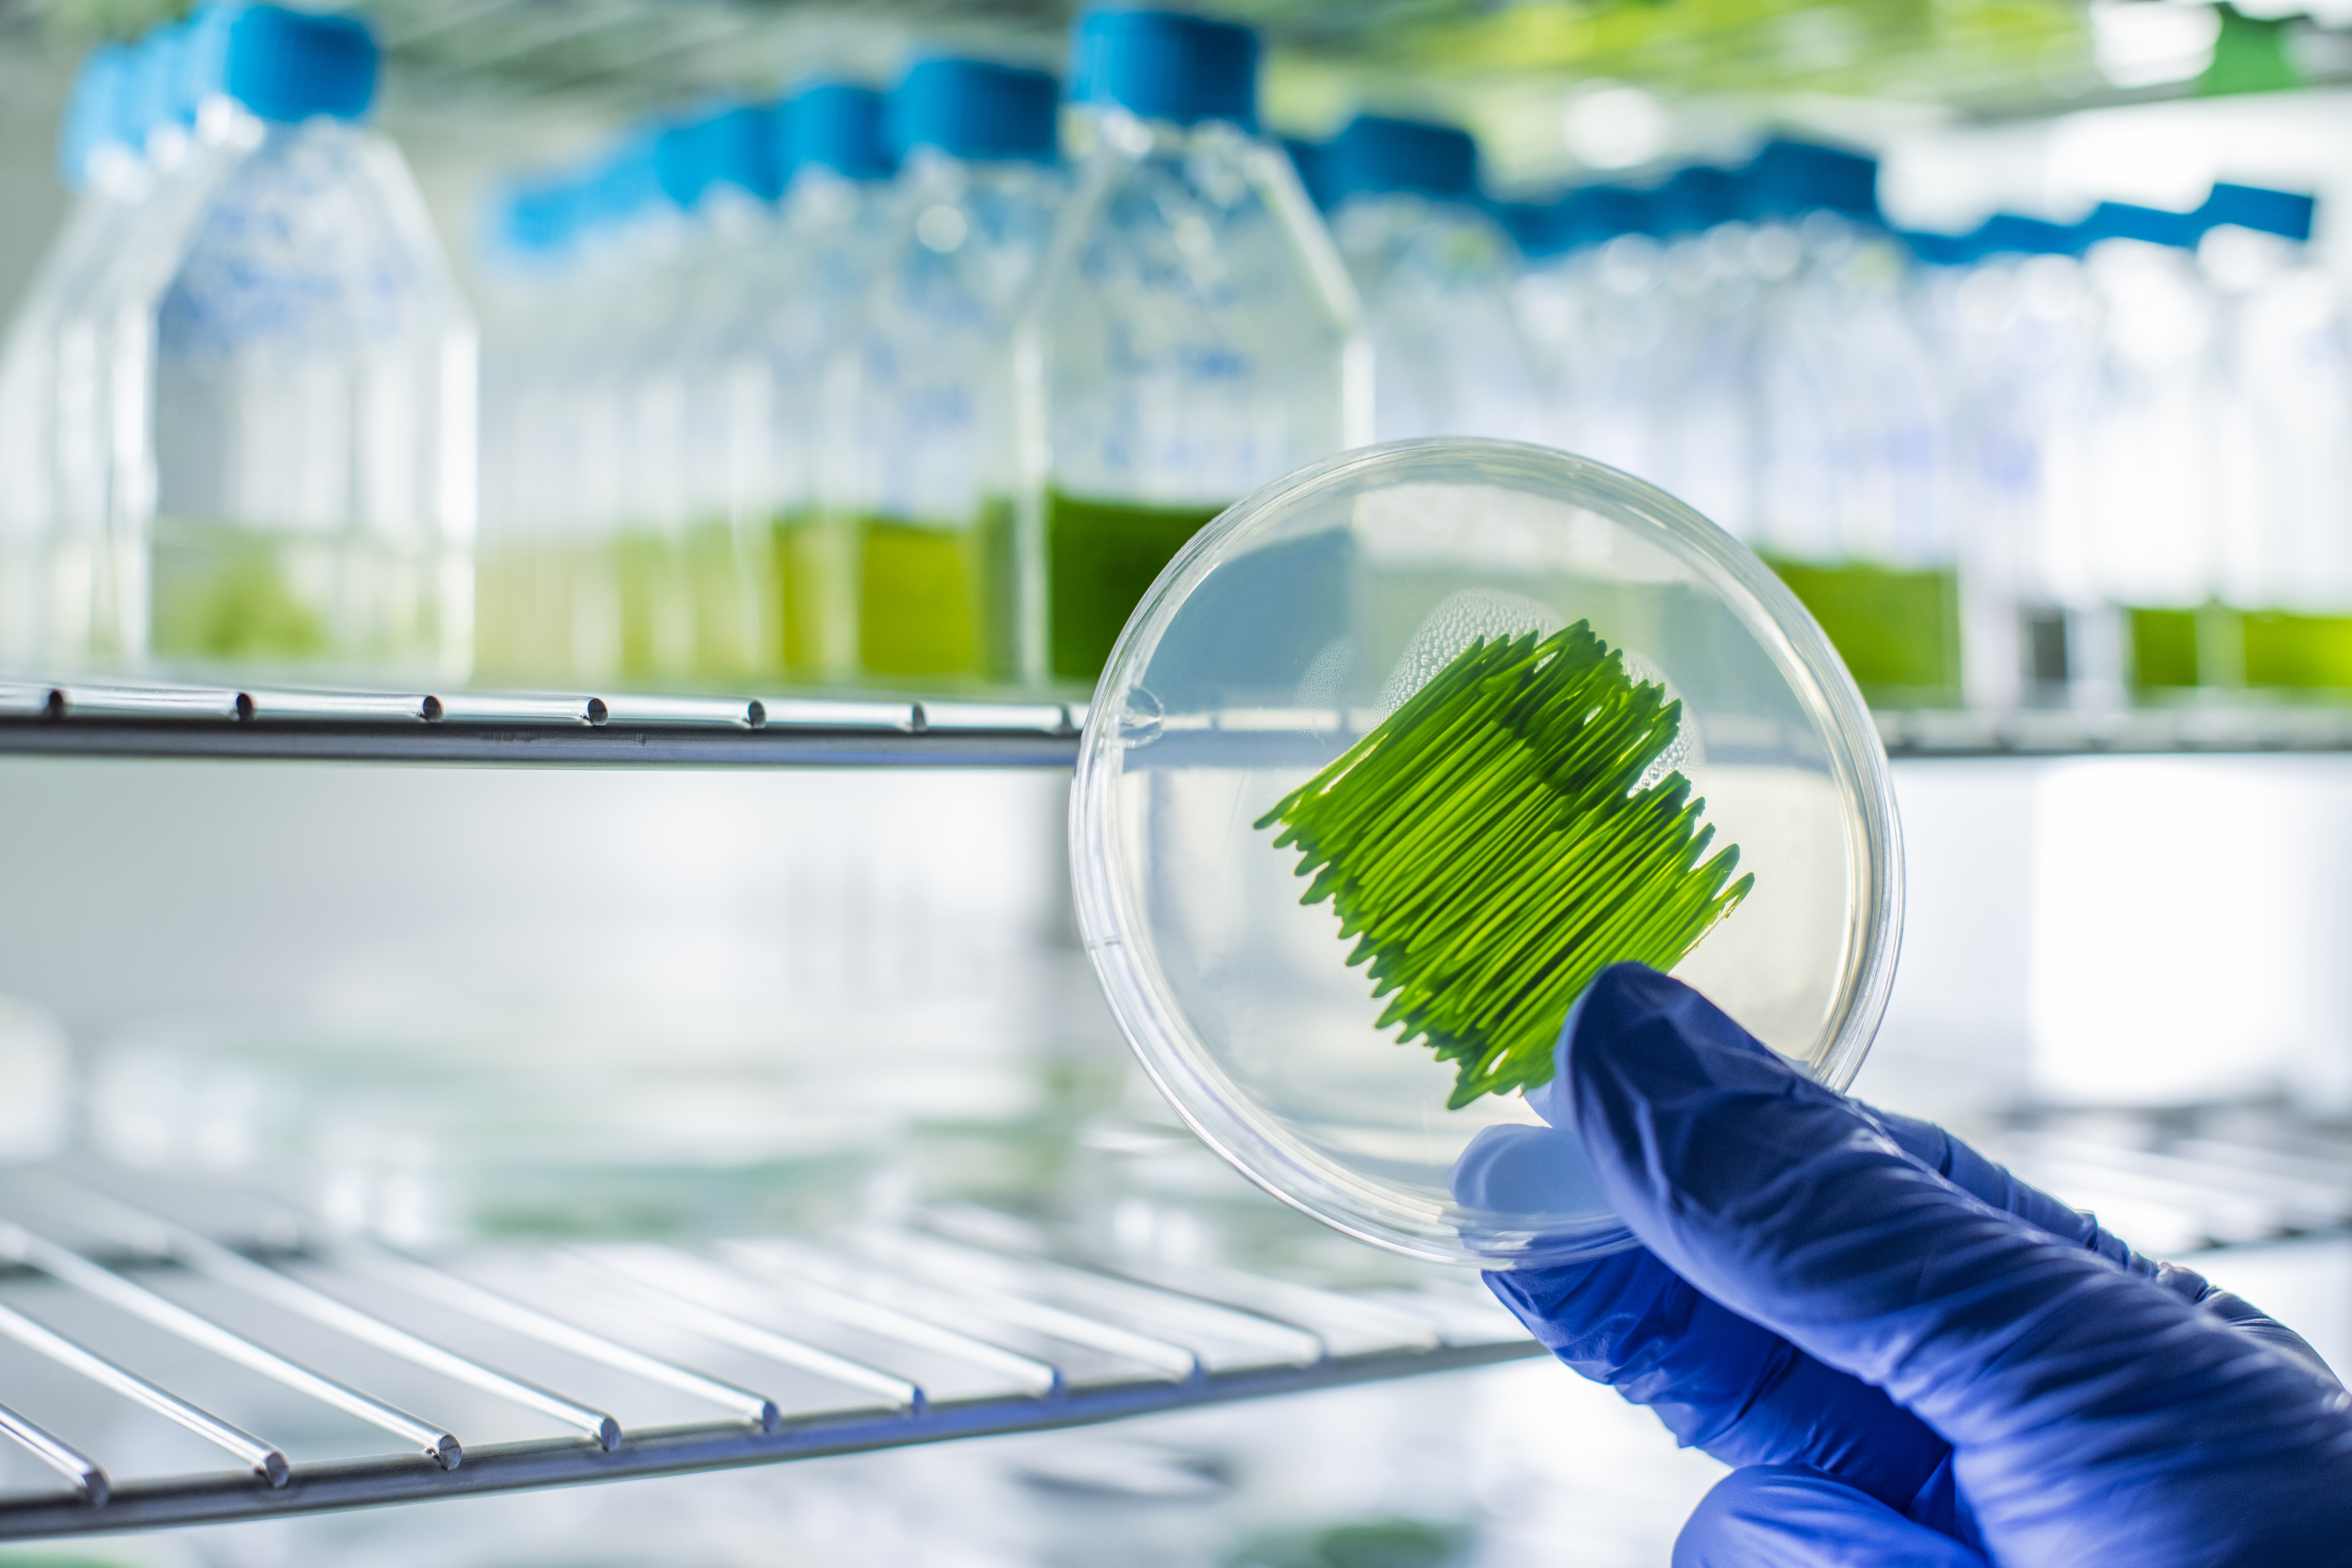
Scientist analyzing microalgae strain on a petri dish

Strain Engineering & AI
Advanced genetic and metabolic engineering of microalgae, accelerated by cutting-edge AI for predictive modeling and strain optimization.
We provide turn-key solutions spanning all aspects of state-of-the-art microalgae applications. From advanced strain engineering to scaled downstream processing, we build the future of sustainable biotechnology for our global partners.
Work With UsScalable Solutions. Measurable Results. Our highly optimized bioreactors demonstrate industrial viability on a global scale.
Advanced genetic and metabolic engineering of microalgae, accelerated by cutting-edge AI for predictive modeling and strain optimization.

Comprehensive upstream and downstream process development. We design, optimize, and scale state-of-the-art laboratory systems tailored to your R&D needs.

Leveraging efficient photobioreactor design for industrial carbon capture, transforming emissions into valuable bioproducts across European and global supply chains.
Developing next-generation biofuels and driving the feasibility of microalgae-based biorefineries to meet rigorous carbon reduction mandates in the aviation sector.
Synthesizing biodegradable plastics and advanced materials from algal biomass to replace petrochemical-based plastics and support a circular economy.
Cultivating high-value nutraceuticals, proteins, and antioxidants for integration into the next generation of health products globally.
From benchtop R&D to full-scale production, Phycotec provides the engineering expertise, equipment design, and facility management to scale your microalgal processes. Our integrated pilot facilities demonstrate commercial feasibility.
